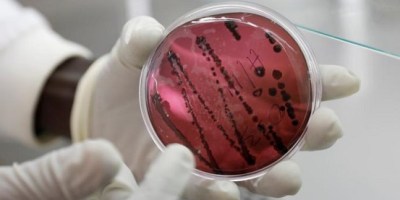

CORONAVIRUS, Información Nacional, salud

Entradas 44

CORONAVIRUS, Información Nacional, salud



Información Nacional, Senado de la República

Dependencias Gubernamentales, Información de los Estados



Estado de México, Información de los Estados


Dependencias Gubernamentales, Información Nacional, Senado de la República



Información Nacional, Senado de la República





Información Nacional, Laboral, Senado de la República


Dependencias Gubernamentales, Información Nacional, Laboral, Presidencia de la República



Educativas, Estado de México, UAEM

Información Internacional, Justicia, SEDENA

Información Nacional, Presidencia de la República

CORONAVIRUS, Información Internacional, salud
Información Internacional, salud

Información de los Estados, Senado de la República



CDMX, seguridad, Seguridad Pública


Dependencias Gubernamentales, ISSSTE

Información Internacional, Presidencia de la República

Información Internacional, Relaciones Exteriores, SRE

Dependencias Gubernamentales, Información Nacional, Justicia, Presidencia de la República

CORONAVIRUS, Información Internacional

Dependencias Gubernamentales, Información Nacional, Presidencia de la República, Senado de la República


CORONAVIRUS, Estado de México, salud



